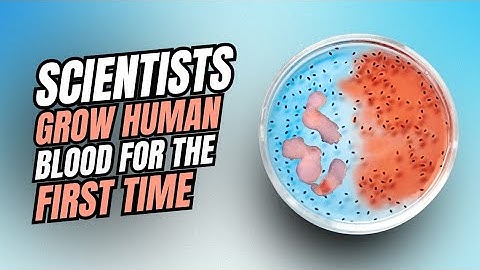
Scientists Grow Human Blood For The First Time 😱 #biology #science #medical #medicine #viralvideo

⬇ DOWNLOAD NOW
Kalau muncul iklan pop-up, tutup lalu klik tombol kembali
Download lagu Artificial intelligence for identification of blood cells - Prof Huiyu Zhou secara gratis hanya untuk keperluan promosi. Dukung artis favorit kamu dengan membeli musik original di iTunes atau platform resmi lainnya.
 Chinese automated #ai phlebobot for blood collection #medical #technology #china
Chinese automated #ai phlebobot for blood collection #medical #technology #china
 How does AI Accelerate The Classification of Blood Cells?
How does AI Accelerate The Classification of Blood Cells?
 This New AI is Made of Living HUMAN BRAIN Cells (Synthetic Biological Intelligence)
This New AI is Made of Living HUMAN BRAIN Cells (Synthetic Biological Intelligence)
 From algorithm to rapid test – Artificial Intelligence classifies blood cells
From algorithm to rapid test – Artificial Intelligence classifies blood cells
 AI could lead to faster, better analysis of donated blood
AI could lead to faster, better analysis of donated blood
 First ever clinical trial of lab-grown red blood cell transfusion
First ever clinical trial of lab-grown red blood cell transfusion
Scientists Grow Human Blood For The First Time 😱 #biology #science #medical #medicine #viralvideo
Scientists Grow Human Blood For The First Time 😱 #biology #science #medical #medicine #viralvideo
 Artificial intelligence: Accelerating discovery in biology research
Artificial intelligence: Accelerating discovery in biology research